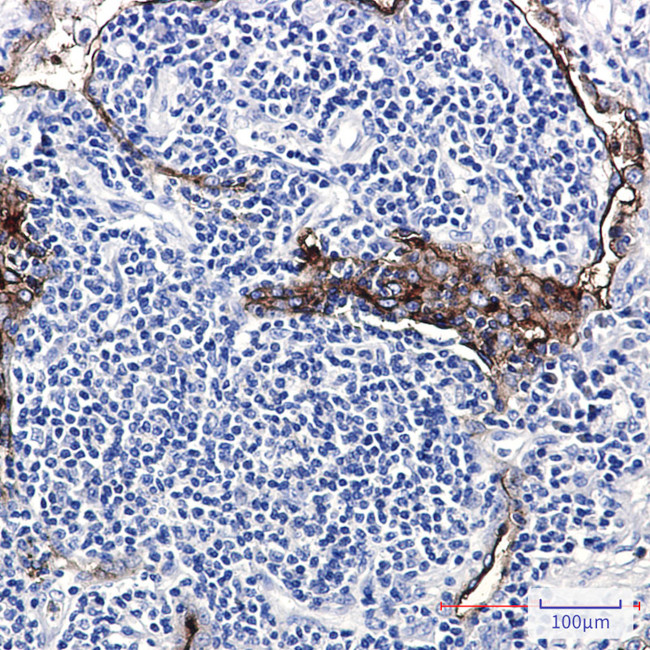
Folate Receptor alpha Antibody in Immunohistochemistry (Paraffin) (IHC (P))

Search
Invitrogen
Folate Receptor alpha Recombinant Rabbit Monoclonal Antibody (K01_1R26)
{{$productOrderCtrl.translations['antibody.pdp.commerceCard.promotion.promotions']}}
{{$productOrderCtrl.translations['antibody.pdp.commerceCard.promotion.viewpromo']}}
{{$productOrderCtrl.translations['antibody.pdp.commerceCard.promotion.promocode']}}: {{promo.promoCode}} {{promo.promoTitle}} {{promo.promoDescription}}. {{$productOrderCtrl.translations['antibody.pdp.commerceCard.promotion.learnmore']}}
图: 1 / 2
Folate Receptor alpha Antibody (MA563763) in IHC (P)


产品信息
MA563763
种属反应
宿主/亚型
Expression System
分类
类型
克隆号
抗原
偶联物
形式
浓度
规格
纯化类型
保存液
内含物
保存条件
运输条件
RRID
靶标信息
The protein encoded by this gene is a member of the folate receptor family. Members of this gene family bind folic acid and its reduced derivatives, and transport 5-methyltetrahydrofolate into cells. This gene product is a secreted protein that either anchors to membranes via a glycosyl-phosphatidylinositol linkage or exists in a soluble form. Mutations in this gene have been associated with neurodegeneration due to cerebral folate transport deficiency. Due to the presence of two promoters, multiple transcription start sites, and alternative splicing, multiple transcript variants encoding the same protein have been found for this gene.
仅用于科研。不用于诊断过程。未经明确授权不得转售。
篇参考文献 (0)
生物信息学
蛋白别名: Adult folate-binding protein; FBP; folate binding protein; Folate receptor 1; folate receptor 1 (adult); Folate receptor alpha; Folate receptor, adult; folate-binding protein precursor; FOLR1; FR-alpha; KB cells FBP; MOv18; Ovarian tumor-associated antigen MOv18
基因别名: FBP; FOLR; FOLR1; FRalpha; NCFTD
UniProt ID: (Human) P15328
Entrez Gene ID: (Human) 2348